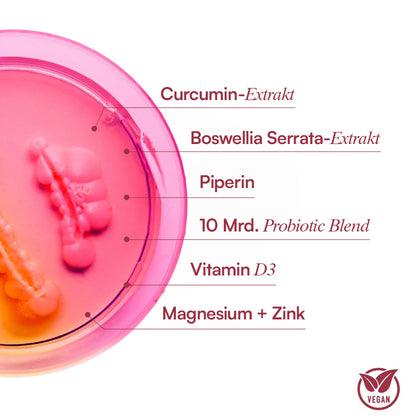

Alina U.





Die kleinen Kapseln haben mir endlich wieder mein Leben zurückgebracht, kann jetzt endlich wieder Durchschlafen. Empfehlenswert!!

Maria P.



Hatte ewig lang mit Angstzuständen zu kämpfen, und habe meine Kinder unnötig angeschrien wegen meiner schlechten Stimmung... Aber das hat jetzt endlich ein Ende, dank Purefemm

Alina U.





Ich könnte ohne Sie nicht mehr Leben. Jeder Alltag in den Wechseljahren war einfach ein Albtraum, seitdem ich das Nahrungsergänzungsmittel nehme konnte ich endlich wie ein normaler Mensch wieder leben.
Wechseljahre complex⁺
Wechseljahre complex⁺
Wechseljahre complex⁺
Wechseljahre complex⁺
Eine hochwirksame Formel aus natürlichen Pflanzenextrakten, Probiotika und Vitaminen – entwickelt, um Gelenkschmerzen und andere typische Beschwerden ganzheitlich zu unterstützen.
Effektive Linderung
- Gelenk-Schmerzen
- Hitzewallungen
- Gewichtszunahme
- Stimmungs-schwankungen
- Nächtliches Schwitzen
- Scheidentrockenheit
- Blähungen
- Energielosigkeit
60 Kapseln | 30 Tage Routine
Nur noch wenige auf Lager
Verfügbarkeit für Abholungen konnte nicht geladen werden
1-3 Tage Lieferzeit | 100% Geld-Zurück-Garantie

Versand
Versand
- Kostenloser Expressversand über 50€
Lieferzeit:
- 1-3 Werktage Lieferzeit nach Deutschland
- 2-5 Werktage Lieferzeit nach Österreich & Schweiz
Alle Bestellungen werden schnell und sicher mit DHL, UPS oder Hermes aus Deutschland versendet.
Inhaltsstoffe
Inhaltsstoffe
Lactobacillus gasseri (4 Mrd. KBE), Lactobacillus rhamnosus (3 Mrd. KBE), Lactobacillus reuteri (2 Mrd. KBE), Bifidobacterium lactis (1 Mrd. KBE), Ashwagandha-Wurzelextrakt (≥5 % Withanolide, 50 mg), Mönchspfeffer-Extrakt (Vitex agnus castus, 10:1, 100 mg), Maca-Wurzelextrakt (10:1, 200 mg), Curcumin-Extrakt (95 % Curcuminoide, 75 mg), Boswellia Serrata-Extrakt (65 % Boswelliasäuren, 100 mg), Piperin (Schwarzer Pfeffer Extrakt, 95 %, 5 mg), Grüntee-Extrakt (≥45 % EGCG, low spec, 200 mg), Chrom (als Chrompicolinat, 200 µg), Vitamin D3 (Cholecalciferol, 25 µg / 1.000 IE), Vitamin K2 (als MK-4, 200 µg), Vitamin B6 (Pyridoxin HCl, 5 mg), Vitamin B12 (Cyanocobalamin, 50 µg), Folsäure (200 µg), Zink (als Zinkgluconat, 10 mg), Magnesium (als Magnesiumcitrat, 30 mg).
Unsere Garantie
Unsere Garantie
Wir lieben unsere Produkte und sind überzeugt, dass sie dir helfen werden!
Für den Fall, dass die Dinge nicht wie geplant laufen, ist unser Rückgaberecht so gestaltet, dass es für dich so einfach wie möglich ist:
Wir bieten eine risikofreie 100-tägige Geld-zurück-Garantie auf alle Einkäufe.

-
Vegan
-
Frei von Gentechnik
-
Hormon frei
-
Versand aus Deutschland
-
Von Experten entwickelt
-
Klinisch getestet
Die Wissenschaft hinter dem Wechseljahre Complex⁺
Die Biologie
Mit den Wechseljahren sinkt der Östrogenspiegel um bis zu 90%. Die Folge: Der Körper produziert bis zu 40% weniger Gelenkschmiere und Hyaluronsäure. Knochen reiben aufeinander statt sanft zu gleiten. Gleichzeitig fördert der Hormonmangel Entzündungen, die Gelenke, Sehnen und Bänder dauerhaft angreifen.
Wie der Wechseljahre Complex⁺ hilft
Der Wechseljahre Complex kombiniert klinisch erforschte Probiotika, Pflanzenextrakte und Mikronährstoffe, die den Gelenkabbau sanft ausgleichen. Die spezifischen Bakterienstämme reduzieren stille Entzündungen im Darm, die sich auf Gelenke ausbreiten. Gleichzeitig liefert die Formel Bausteine für Kollagen und Gelenkschmiere. So können steife Finger wieder greifen, Knie wieder Treppen steigen und morgendliche Steifigkeit spürbar nachlassen.
Verifizierter Kunde
Sophie O.
War mental und körperlich echt am Ende. Die Gelenkschmerzen haben mich nachts wachgehalten und tagsüber konnte ich kaum noch normal laufen. Nach einem Monat mit dem Wechseljahre Complex hab ich gemerkt dass sich was tut - nicht nur die Schmerzen wurden weniger sondern auch im Kopf. Nach 6 Monaten sind die Schmerzen zu 95% weg und ich fühl mich wieder wie mein altes Ich
100.000+ Frauen sagen Ja zu Wechseljahre Complex+!
Selbst Experten empfehlen es ihren Patientinnen.
Verifizierter Kunde
Hildegard P.
Eigentlich bin ich ein fröhlicher Mensch aber über Monate hatte ich nur diese Gelenkschmerzen im Kopf. Morgens aufstehen war die Hölle, Hände steif, Knie taten weh. Seit ich die Wechseljahre Kapsel nehme ist nicht nur die Schmerzen besser - die ganze Stimmung ist wieder da. Die Fingergelenke sind nicht mehr geschwollen und ich hab wieder Energie. Endlich fühl ich mich wieder wie ich.
Verifizierter Kunde
Sarah Z.
War super skeptisch aber hab's aus Verzweiflung probiert. Seit der Menopause hab ich gefühlt jeden Monat zugenommen an Schmerzen - Hüfte, Knie, dann die Hände. Nach zwei Wochen hab ich tatsächlich einen Unterschied gemerkt - vor allem morgens bin ich nicht mehr so steif. Nach 8 Wochen jetzt sind die Schmerzen deutlich weniger. Bin echt überrascht dass es funktioniert hat. Bleib dabei.
Klinisch geprüfte Inhaltsstoffe, die gezielt hormonelle Gelenkschmerzen unterstützen
Klicke einfach auf den jeweiligen Inhaltsstoff um mehr über Wirkung, Studien und Anwendung zu erfahren
-
Curcumin Extrakt
Reduziert Entzündungen in
Gelenken, lindert Schmerzen
und unterstützt Beweglichkeit in den Wechseljahren.+ -
Boswellia Serrata Extrakt
Fördert auf natürliche Weise Produktion von Estrogen, Energie und Vitalität
+ -
Piperin
Steigert die Aufnahme von
Curcumin und verstärkt seine Wirkung.+ -
10 Mrd. KBE Probiotic Blend
Unterstützt die Reduktion stiller Entzündungen, stärkt die Abwehrkräfte und kann dadurch Gelenkbeschwerden lindern.
+ -
Vitamin D3 + K2
Trägt zum Erhalt gesunder Knochen und Muskeln bei – eine wichtige Basis für starke Gelenke ohne Schmerzen.
+ -
Magnesium + Zink
Unterstützt Muskeln, Knochen und Bindegewebe, reduziert Krämpfe und trägt so zu weniger Gelenkbelastung bei.
+
Curcumin Extrakt
Qualitätskontrolle
Placebo-kontrolliert – Ja
In vivo – Ja
Peer-reviewed – Ja
Statistisch signifikant – Ja
Zusammenfassung der wichtigsten Studie
In einer randomisierten, placebokontrollierten Studie erhielten Patienten mit Kniearthrose acht Wochen lang Curcumin oder ein Placebo. Die Curcumin-Gruppe berichtete über deutlich weniger Schmerzen und bessere Beweglichkeit als die Placebo-Gruppe.
Boswellia Serrata Extrakt
Ein traditionelles Harz, das Entzündungsprozesse hemmt und die Beweglichkeit bei Gelenkproblemen fördert.
Qualitätskontrolle
Placebo-kontrolliert – Ja
In vivo – Ja
Peer-reviewed – Ja
Statistisch signifikant – Ja
Zusammenfassung der wichtigsten Studie
In einer 90-tägigen, randomisierten Studie erhielten Patienten mit Arthrose Boswellia-Extrakt oder ein Placebo. Bereits nach vier Wochen zeigten sich deutliche Verbesserungen bei Schmerz und Gelenkfunktion in der Boswellia-Gruppe.
Piperin
Erhöht die Aufnahme von Curcumin im Körper massiv und verstärkt somit dessen Wirkung auf Entzündungen und Schmerzen.
Studien Merkmale
Placebo-kontrolliert – Ja
In vivo – Ja
Peer-reviewed – Ja
Statistisch signifikant – Ja
Zusammenfassung der wichtigsten Studie
In einer klinischen Studie erhöhte die gleichzeitige Einnahme von Piperin die Bioverfügbarkeit von Curcumin um das 20-Fache im Vergleich zur Einnahme von Curcumin allein.
10 Mrd. KBE Probiotic Blend
Ein probiotischer Mix, der das Immunsystem unterstützt und entzündliche Prozesse im Körper regulieren kann.
Zusammenhängende Studien
Placebo-kontrolliert – Ja
In vivo – Ja
Peer-reviewed – Ja
Statistisch signifikant – Ja
Zusammenfassung der wichtigsten Studie
In einer kontrollierten Studie mit Frauen nach der Menopause führte die Einnahme von Probiotika zu einer deutlichen Reduktion von Entzündungsmarkern im Blut im Vergleich zur Kontrollgruppe.
Vitamin D3 + K2
Qualitätskontrolle
Placebo-kontrolliert – Ja
In vivo – Ja
Peer-reviewed – Ja
Statistisch signifikant – Ja
Zusammenfassung der wichtigsten Studie
In einer RCT mit älteren Erwachsenen reduzierte die Supplementierung von Vitamin D und K den Knochenverlust signifikant und trug zu stärkerer Knochengesundheit bei als Placebo.
Magnesium + Zink
Qualitätskontrolle
Placebo-kontrolliert – Ja
In vivo – Ja
Peer-reviewed – Ja
Statistisch signifikant – Ja
Zusammenfassung der wichtigsten Studie
In einer Bevölkerungsstudie war eine höhere Magnesiumaufnahme mit einer signifikant besseren Knochendichte und einem geringeren Risiko für Osteoarthritis verbunden. Ähnliche Ergebnisse wurden für Zink beobachtet.
-
Zwei Kapseln einmal täglich
-
Zu jeder Tageszeit
-
Nach einer Mahlzeit
Jetzt risikofrei testen mit unserer 100-Tage-Geld-zurück-Garantie!

Die Wissenschaft, Ärzte und unsere Kunden sind sich einig: Der Wechseljahre Complex wirkt!
Deshalb bieten wir eine 100-tägige, risikofreie Geld-zurück-Garantie an!
Solltest du, aus egal welchem Grund, keine Ergebnisse erzielen oder es dir einfach anders überlegt haben, bekommst du eine volle Rückerstattung.
In anderen Worten: Du zahlst nur, wenn Purefemm dich zu 100 % überzeugt!
100 Tage-Geld-Zurück-Garantie
Erfahre was Experten über uns sagen
Bei Purefemm verwenden wir sorgfältig ausgewählte Inhaltsstoffe, die wissenschaftlich fundiert sind und höchste Reinheit und Wirksamkeit bieten.
“Purefemm liefert zuverlässige Lösungen Frauen in von Frauen die Hormonelle Balance zu zu unterstützen”
Dr. Swati Pund PhD in Pharmazeutische Wissenschaften
„Purefemm bietet- eine durchdachte, wissenschaftlich fundierte Lösungen, die Frauen wirklich hilft.“
Dr. Shan Shakeel Doktortitel in Allgemeiner Medizin
Häufig gestellte Fragen
01 Wie lange dauert der Versand und von wo wird versendet?
Alle Produkte werden aus unserem Lager in Deutschland versendet. Die Lieferzeit setzt sind auch 2 verschiedenen Zeiten zusammen:
1) Bearbeitungszeit:
1-2 Werktage
2) Versandzeit:
Deutschland: 1-3 Werktage
Österreich: 3-5 Werktage
Schweiz: 3-5 Werktage
02 Wie werden die Kapseln eingenommen?
Wir empfehlen 2x Kapseln täglich nach einer Mahlzeit, zu sich zu nehmen. Die Kapseln sollte jeden Tag über mehrere Monate konsumiert werden, um die richtigen Ergebnisse zu sehen.
03 Wie lange kann ich retournieren?
Wir bieten eine risikofreie 100 Tage Geld Zurück Garantie auf alle Bestellungen an. Falls du unzufrieden bist schreib und einfach eine e-mail an info@purefemm.com und lass es uns gut machen.
04 Gibt es Nebenwirkungen?
Zum jetzigen Zeitpunkt sind uns keine Nebenwirkungen bekannt, falls du jedoch jegliche Nebenwirkungen entwickeln solltes konsultiere einen Arzt und stoppe die Einnahme sofort.
05 Wie lange dauert es bis ich Ergebnisse spüre?
Der Körper eines jeden Menschen ist einzigartig, daher können die Ergebnisse variieren.
Während einige Kunden bereits nach 2 Wochen erste Ergebnisse sehen, dauert es in der Regel 8-12 Wochen, bis die Kapseln ihre vollständige Wirkung gezeigt haben.
Deshalb empfehlen wir, das 3-Monatspaket oder 6-Monatspaket auszuprobieren, um in den vollen Genuss der Vorteile zu kommen.